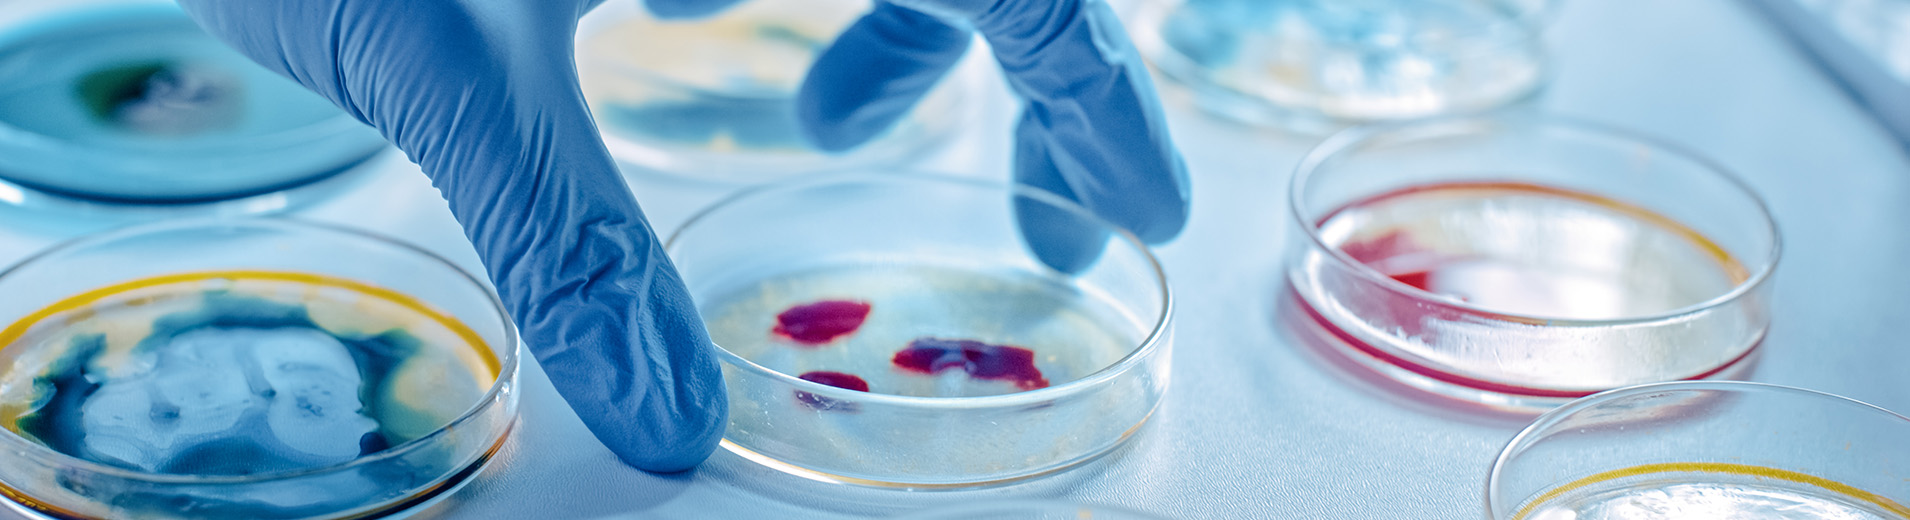

Billy LaFortune
AssociateBilly LaFortune focuses his practice on corporate transactions, including mergers & acquisitions, divestitures, equity investments, cross-border transactions, venture capital financings and general corporate counselling.
He has experience representing both private and public companies, as well as strategic investors, in a variety of industries.
Pro Bono
Billy regularly works on pro bono matters involving representation of military veterans. Billy also provides legal services and corporate guidance to local non-profits and small businesses.
- J.D., University of Notre Dame Law School
cum laude
Faculty Awards for Excellence: Sports Law, International Law - B.S., Finance, University of Tulsa
Prior Experience
While at Notre Dame Law School, Billy worked as a student lawyer with the Community Development Clinic and assisted in providing legal services to local small businesses and non-profits.
Prior to law school, Billy worked in the energy industry for over three years.